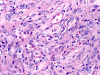
Com406-1-1.gif (159567 bytes)

Reticulin




Synaptophysin
NeuN
GFAP
HMB45
| A 5 month-old Boy
with a Superficially Located,
Partially Cystic Hemispheric Mass. June, 2004, Case 406-1. Home Page |
Kar-Ming Fung, M.D., Ph.D. 1, Arie Perry, M.D. 2 Last update: July 30, 2004.
1 Department of Pathology, University of Oklahoma Health Sciences Center, Oklahoma City, Oklahoma, and 2 Department of Pathology, Washington University, St. Louis, Missouri
Clinical information: The patient was a 5-month old African American boy who presented with constant turning of the head to the left. He also had a day of vomiting, diarrhea, and a single seizure. Imaging revealed a large superficial, partially cystic, enhancing cerebral left hemispheric mass.
 |
|
 |
 |
||
| A. | B. | C. |
D. Reticulin |
||
 |
 |
 |
 |
||
|
E. Synaptophysin |
F. NeuN |
G. GFAP |
H. HMB45 |
SYN: Synaptophysin; GFAP: Glial fibrillary acidic protein.
Pathology of the case:
At low magnification, the lesion appears as a spindly, desmoplastic neoplasm with storiform arrangement that could be seen in some mesenchymal tumors (Panel A). On higher magnification, the overall pleomorphism is relatively mild. Mitotic figures are not readily seen. There are some round to triangular cells that are surrounded by a rim of retraction artifactual space from the surrounding desmoplastic component (Þ in Panel B). These cells seem like a drop of oil floating on water. The morphologic features of these cells are suggestive of ganglionic cells and/or gemistocytic astrocytes. In other areas, tumor cells containing melanin pigment (Panel C) are present. Deposition of reticulin material can be seen essentially around every single cells (Panel D). Scattered within the tumors are large ganglionic that can be well demonstrated by immunohistochemistry for synaptophysin (Panel E). Tumor cells with mature neuronal phenotype is also immunoreactive for NeuN (Panel F). Immunohistochemistry should that the amount of astrocytic cells far out numbered ganglionic cells (Panel G). Cells that express melanin are also strongly positive for HMB45 on immunohistochemistry.
| DIAGNOSIS: Desmoplastic Infantile Ganglioglioma (DIG) with melanocytic colonization. |
Discussion: General Information Pathology Melanotic cells in tumor Differential diagnosis
General Information
The term desmoplastic infantile ganglioglioma (DIG) was first proposed by VandenBerg et al. 1. DIG is a WHO grade I neroepithelial tumor with prominent desmoplastic stroma and a neuroepithelial population. The neuroepithelial component is composed predominantly of neoplastic astrocytes and a variable amount of neuronal (ganglionic) complonents. Poorly differentiated component with features similar to that of medulloblastoma or supratentorial primitive neuroectodermal tumor (PNET) can also be part of the tumor 2. When there is a lack of neuronal component, the term desmoplastic infantile astrocytoma (DIA), or formely desmoplastic cerebral astrocytoma of infancy (DCAI), is used 3, 4, 5. It should be noted that desmoplastic ganglioglioma and desmoplastic astrocytomas can occur in older patient and “infantile” might not be totally appropriate for these tumor although they behave often in a benign fashion similar to DIG and DIA. Some pathologist also accept DIA as a variant of DIG with ganglion cells that are too difficult to be found.
DIG and DIA are uncommon tumors. The majority of these tumors occur before the age of ten and they are slightly more common in male. Typically, they occur as superficially located, supratentorial dural attached, contrast enhancing mass with unilocular or multiloculated cysts. These tumors tend to be large tumor and often involve more then one lobe with the frontal and parietal lobes among the most commonly involved. They appear very heterogeneous on MR imaging due to the heterogeneous collagenous component and cystic components. The desmoplastic component is hypointense on T2-weighed images and is strongly enhancing. This MR appearance may also suggest supratentorial PNET or gliosarcoma.
Due to their large size and their common occurrence in infants, the clinical manifestations are that of hydrocephalus. The symptoms and signs include increasing head circumference, tense and bulging fontanelles, and forced downward ocular deviation (“sunset gaze”). Seizures, paralysis, and increased muscle tone can be part of the clinical picture. Despite their large size and the presence of undifferentiated components in some cases, gross total resection results in long term survival in most cases.
Macroscopically, DIG and DIA are large tumor that may measure up to 13 cm in diameter. The uni- or multiloculated cyst contain clear or xanthochromatic fluid. The desmoplastic component is firm or rubbery in consistency and is attached to the dura and leptomeninges. Due to their desmoplastic nature, a cytologic preparation of these specimen during intraoperative consultation is not always possible.
Microscopically, the desmoplastic activity is so widespread that it would suggest sarcomas to the novices. Recognition of this potential pitfall is of importance during intraoperative consultations. DIA and DIG have known tendency to extend into the Vichow-Robin space. However, there is a typical, marked demarcation between the desmoplastic tumor and the cortex. Spindle cells arranged in fascicles, storiform, or wholed pattern intermixed with collagenous component are common findings and is particularly associated in areas with leptomeningeal involvement. On detailed examination, neoplastic neuroepithelial cells with features of astrocytes, gemistocytic astrocytes, and neurons (ganglion cells) are common. It is very common that the gemistocytic astrocytes and ganglionic cells have a retraction, artifactual space at their cytoplasmic border. These large cells appear like drops of oil in water (i.e., the desmoplastic component). The collagenous component will stain blue and the neuroepithelial component will stain pink or red on Masson’s trichrome. A reticulin stain will show deposition of reticulin material around individual tumor cells. Significant nuclear pleomorphism is not a usual feature of these tumors. Mitosis is quite uncommon and the Ki-67 labeling index for cyclinc cells ranges from less than 0.5% to 5% 2. Necrosis and endothelial proliferation should not be seen. The glial component can be well demonstrated by immunohistochemistry for GFAP. The ganglionic component can be well demonstrated by immunohistochemistry for synaptophysin, neurofilament proteins, synaptophysin, NeuN, class III beta-tubulin and MAP2.
DIA and DIG, however, can also harbor undifferentiated cellular components that have morphologic features of medulloblastoma and suprtentorial PNETs. These components are often mitotically active and have high Ki-67 labeling index.
Melanotic differentiation in neuroepithelial tumor is not a common but a well described phenomenon. Melanocytic differentiation has been reported in a variety of primary neuroepithelial neoplasms with embryonal morphology or neuronal differentiation. These tumors include melanotic medulloblastoma 6, neuroblastoma 7, ganglioneuroblastoma 8, central neurocytoma 9, olfactory neuroblastoma 10 and paraganglioma 11. Melanotic differentiation has also been described in non-neuronal, non-embryonal neuroepithelial tumors such as ependymoma 12 and choroids plexus carcinoma 13. The melanotic variants of these neuroepithelial tumors do not usually behave substantially different from their non-pigment counterparts.
Although melanotic differentiation is one way to explain the presence of melanocytic cells in the tumor under discussion, the melanocytic cells may also represent colonization by melanocytes that are recruited from the leptomeninges. Embryologically, the neurocrest cells are the origin of the telencephalic leptomeninges and also melanocytes that populate the skin and other tissues including the leptomeninges. An increased density of melanocytes in the leptomeninges is commonly found in people with dark skin and the patient under discussion is an African American. In fact, melanocytic colonization has been described in a meningioma that is taken from a 70 year-old African American patient 14. Similar melanocytic colonization has been described in non-melanocytic tumors arising in skin and breast where recruitment of melanocytes seems to be possible 15, 16.
On one hand, melanotic differentiation is not uncommon in neuroepithelial tumors with glial and/or neuronal component. The melanotic cells in the tumor under discussion may well represent melanotic differentiation of the neuroepithelial component. From the morphological point of view, however, the melanotic cells under discussion appear small, elongated and somewhat similar to melanocytes that could be seen in leptomeninges. When these features are interpreted in conjunction with tumor involvement of the leptomeninges in a dark skinned person (African American) as in the current case, the possibility of melanocytic colonization by non-neoplastic leptomeningeal melanocytes seems equally possible.
Differential diagnosis
The histologic features at the time of frozen sections and on brief examination of permenant sections invariably suggest mesenchymal tumors. Knowing the young age of the patient, its characteristic MR imaging characteristics, and recognizing the existence of DIG and DIA would promptly clear the confusion. Immunohistochemical demonstration of the glial and neuronal component by immunohistochemistry will help recognition of DIG and DIA. In addition, DIA and DIG typically lacks features of high-grade tumors such as necrosis, brisk mitotic activity and substantial pleomorphism. When these features are present, a possibility of sarcomas or gliosarcoma must be entertained. Metastatic sarcomas, although rare, should not be overlooked and a positive clinical history would be helpful. It should also be noted that sarcomas of the central nervous system, primary or secondary, tend to occur in older adults rather than infants.
Glioblastoma with desmoplastic changes and gliosarcoma can be a little more difficult to be separated from DIG and DIA for their partial overlap in age and presence of astrocytic components. Again, the high-grade features should only be seen in glioblastoma and gliosarcoma. In addition, histologically benign areas that can be identified in DIG and DIA reassure the benign nature of these tumors.
Last but not the least, the undifferentiated components have features of medulloblastoma or supratentorial PNETs, desmoplastic changes with astrocytic and ganglionic differentiation is not a feature of medulloblastoma and supratentorial PNETs.
Reference:
VandenBerg SR, May EE, Rubinstein LJ, Herman MM, Perentes E, Vinores SA, Collins VP, Park TS. Desmoplastic supratentorial neuroepithelial tumors of infancy with divergent differentiation potential ("desmoplastic infantile gangliogliomas"). Report on 11 cases of a distinctive embryonal tumor with favorable prognosis. J Neurosurg. 1987; 66:58-71.
Taratulo AL, VandenBerg SR, Rorke LB. Desmoplastic infantile astrocytoma and ganglioma. World Health Organization Classification of Tumours- Tumours of the Nervous System. Kleihues P and Cavenee WK. IARC Press, 2000. Page 99-102.
Aydin F, Ghatak NR, Salvant J, Muizelaar P. Desmoplastic cerebral astrocytoma of infancy. A case report with immunohistochemical, ultrastructural and proliferation studies. Acta Neuropathol (Berl). 1993; 86:666-70.
de Chadarévian JP, Pattisapu JV, Faerber EN. Desmoplastic cerebral astrocytoma of infancy. Light microscopy, immunocytochemistry, and ultrastructure. Cancer. 1990; 66:173-9.
Louis DN, von Deimling A, Dickersin GR,
Dooling EC, Seizinger BR. Desmoplastic cerebral astrocytomas of
infancy: a histopathologic, immunohistochemical, ultrastructural, and
molecular genetic study.
Hum Pathol. 1992; 23:1402-9.
Dolman CL. Melanotic medulloblastoma. A case report with immunohistochemical and ultrastructural examination. Acta Neuropathol (Berl). 1988; 76:528-31.
Mullins JD. A pigmented differentiating neuroblastoma: a light and ultrastructural study. Cancer. 1980; 46:522-8.
Hahn JF, Netsky MG, Butler AB, Sperber EE. Pigmented ganglioneuroblastoma: relation of melanin and lipofuscin to schwannomas and other tumors of neural crest origin. J Neuropathol Exp Neurol. 1976 Jul;35(4):393-403.
Ng TH, Wong AY, Boadle R, Compton JS. Pigmented central neurocytoma: case report and literature review. Am J Surg Pathol. 1999; 23:1136-40.
Curtis JL, Rubinstein LJ. Pigmented olfactory neuroblastoma: a new example of melanotic neuroepithelial neoplasm. Cancer. 1982;49: 2136-43.
Lack EE, Kim H, Reed K. Pigmented ("black") extraadrenal paraganglioma. Am J Surg Pathol. 1998; 22: 265-9.
Chan AC, Ho LC, Yip WW, Cheung FC. Pigmented ependymoma with lipofuscin and neuromelanin production. Arch Pathol Lab Med. 2003;127:872-5.
Boesel CP, Suhan JP. A pigmented choroid plexus carcinoma: histochemical and ultrastructural studies. J Neuropathol Exp Neurol. 1979; 38:177-86.
Nestor SL, Perry A, Kurtkaya O, Abell-Aleff P, Rosemblat AM, Burger PC, Scheithauer BW. Melanocytic colonization of a meningothelial meningioma: histopathological and ultrastructural findings with immunohistochemical and genetic correlation: case report. Neurosurgery. 2003; 53:211-4.
Lambert MW, Lambert WC, Schwartz RA, Mesa ML, Brodkin RH, Abbey AH, Potter GK, Little WP Jr. Colonization of nonmelanocytic cutaneous lesions by dendritic melanocytic cells: a simulant of acral-lentiginous (palmar-plantar-subungual-mucosal) melanoma. J Surg Oncol. 1985; 28:12-8.
Fernandez-Figueras MT, Puig L, Casanova JM, Musulen E, Matias-Guiu X, Navas-Palacios JJ. Pigmented epidermotropic ductal carcinoma of the breast in a male. Ultrastructural evidence of melanocytic colonization and melanin transfer to the tumor. J Cutan Pathol. 1995; 22:276-80.